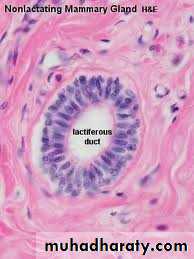

بسم الله الرحمن الرحيم
Prof.Dr. Huda Al-Khateeb
Head of Quality Assurence & Academic PerformanceHead of Histology section/Dept. of Anatomy
College of Medicine/ Univ. of Baghdad
hmdk54@yahoo.com
FEMALE REPRODUCTIVE SYSTEM
To study the histology of
1.Uterus and cervix2.Placenta
3.Vagina
4. Mammary gland
objectives
is a pear-shaped organ with thick, muscular walls. It has 3 parts
1.Body: largest part, the body2. Fundus: upper dom-shape part
3. Cervix: lower most part
Uterus
The uterine wall has three major layers:
1.The endometrium (mucosa): the inner most layer2.The myometrium (muscular layer)
3.The perimetrium : outer connective tissue layer
Uterus
Composed of
1.Simple columnar epithelium ulternating ciliated and secretory
2.Lamina propria: loose connective tissue (mostly cellular). Contains uterine glands
EndometriumSimple columnar epithelium ulternating ciliated and secretory
penetrate the full thickness of the endometrium
They are strait in the proliferative phase of menstrual cycle and tortous in the secretory phase.Uterine glands
It is subdivided into two zones.
(1) The basal layer adjacent to the myometrium, contains highly cellular lamina propria and the deep basal ends of the uterine glands.(2) The superficial functional layer (or functionalis) contains more spongy and less cellular lamina propria, richer in ground substance, most of the length of the glands, as well as the surface epithelium.
The functional layer undergoes profound changes during the menstrual cycles, but the basal layer remains relatively unchanged.
Endometrium
The blood vessels supplying the endometrium are of special significance in the periodic sloughing of the functional layer during menses.
1.Arcuate arteries in the middle layers of the myometrium send two sets of smaller arteries to the endometrium
2. straight arteries, which supply only the basal layer
3. long, progesterone-sensitive spiral arteries, which extend farther and bring blood throughout the functional layer.
Spiral arteries branch with numerous arterioles supplying a rich capillary bed that includes many dilated, thin-walled vessels called vascular lacunae
Endometrium blood supply
The myometrium (Gr. myo, muscle, + metra, uterus), the thickest layer of the uterus, is composed of bundles of smooth muscle fibers that form four interwoven, poorly defined layers.
Myometrium
During pregnancy, the myometrium goes through a period of extensive growth involving both hyperplasia (increasing the number of smooth muscle cells) and hypertrophy (increasing cell size). During this growth, many of the smooth muscle cells also actively synthesize collagen, strengthening the uterine wall.
Myometrium
After pregnancy, uterine smooth muscle cells shrink and many undergo apoptosis, with removal of unneeded collagen, and the uterus returns almost to its prepregnancy size.
Myometrium
From the time of puberty until menopause, the endometrium to undergo cyclic structural changes during the menstrual cycle.The duration of the menstrual cycle is variable but averages 28 days.
Menstrual Cycle
1.The menstrual period of the cycle lasts 3–4 days on average.
2.The proliferative phase, is of variable length, 8–10 days on average3.The secretory phase begins at ovulation and lasts about 14 days.
Phases of the menstrual cycle
After the menstrual phase, the uterine mucosa is relatively thin (about 0.5 mm).
Ovary is characterized by folliculogenesis and estrogen secretionProliferative (Follicular) (Estrogenic) phase
Estrogens act on the endometrium, inducing cell proliferation and reconstituting the functional layer lost during menstruation.
During the proliferative phase, the uterine glands are relatively straight tubules with narrow, nearly empty lumens.
At the end of the proliferative phase, the endometrium is 2–3 mm thick.
Proliferative Phase
Ovary shows corpus luteum formation and progesterone secretion.
Progesterone stimulates epithelial cells of the uterine glands and they become highly coiled during this period.The endometrium reaches its maximum thickness (5 mm)
Secretory (Luteal) (Progesteronic)phase
Ovary shows corpus albicans formation and reduction of estrogen and progesterone
Endometrium reveals sheding of the functional layerMenstrual Phase
Endometriosis is a fairly common disorder in which the endometrial tissue is found in uterine tubes, uterus, ovarian surface, or peritoneal lining.
Under the influence of estrogen and progesterone, the ectopic tissue grows and degenerates monthly without effective removal, leading to pain, inflammation, cysts, adhesions, and scar tissue that can result in infertility.
Medical Application
Composed of
1.Fetal part-Amnion
Chorionic plate
2.Villi and intervillus space
3.Maternal part
placenta
1 - amnion2 - chorionic plate3 - chorionic villi4 - placental septum (excrescence from decidua basalis)5 - decidua basalis
The placenta is also an endocrine organ, producing HCG,
chorionic thyrotropin,chorionic corticotropin,
estrogens,
progesterone,
and other hormones.
placenta
The cervix is the lower, more cylindrical part of the uterus and it differs in histologic structure from the rest of the uterus.
It is composed of 2 parts
(1)Endocervix – cervical canal, ext. os and int. os
(2)Ectocervix – pulging into vagina
.
Uterine Cervix
The endocervix is lined by a mucus-secreting simple columnar epithelium on a thick lamina propria.
The ectocervix is lined by stratified squamous nonkeratenized epithelium.
A distinct junction, or transformation zone, occurs where the simple columnar epithelium undergoes an abrupt transition to stratified squamous epithelium.
Uterine Cervix
The endocervical mucosa contains many branched cervical glands, which produce mucus.
However, this mucosa is affected histologically much less than the endometrium and it does not shade during menstruationUterine Cervix
The deeper, middle layer of the cervix has little smooth muscle and consists mainly of dense connective tissue.
Uterine Cervix
Cervical secretions change cyclically.
At the time of ovulation, the mucous secretions are maximal, watery, and facilitate movement through the uterus by sperm. In the luteal phase high progesterone levels cause the mucous secretions to become viscous and hinder the passage of both sperm and microorganisms into the body of the uterus. During pregnancy, the cervical glands proliferate and secrete abundant, highly viscous mucus which forms a plug in the endocervical canalUterine Cervix
Before parturition the cervix dilates greatly and softens due to intense collagenolytic activity in the stroma
Uterine Cervix
Cancer of the cervix (cervical carcinoma) is derived from its stratified squamous epithelium ( at transformation zone).
Although it is observed fairly frequently, the mortality rate is decreasing rapidly worldwide because this carcinoma is now usually detected in its early stages by routine screening programs.
MEDICAL APPLICATION
For such tests cervical cells are studied by exfoliative cytology, using cells that have been scraped with a brush or wooden spatula from the cervix, especially from the region of the junction between the simple columnar and stratified epithelia, stained on a slide and examined microscopically. Abnormal cells suggestive of precancerous changes in the epithelium are detected in such "cervical smears" or "Pap smears,"
MEDICAL APPLICATION
exfoliative cytology
Abnormal cell growth (dysplasia) with the possibility of progressing to carcinoma (neoplasia) occurs most commonly at the transformation zone between the columnar and stratified epithelia, especially when the cells also contain the human papillomavirus (HPV), which is very common
MEDICAL APPLICATION
The wall of the vagina lacks glands and consists of three layers:- 1.mucosa: stratified squamous epithelium and lamina propria
2.muscular layer
3.adventitia.
Mucus covering the lumen of the vagina is produced by the glands of the uterine cervix.
Vagina
The epithelium of the vaginal mucosa is stratified squamous non-keratinized, with a thickness of 150–200 m in adults.
Stimulated by estrogens, the epithelial cells synthesize and accumulate glycogen. When the cells desquamate, bacteria metabolize glycogen to lactic acid, causing a relatively low pH within the vagina which helps provide protection against pathogenic microorganisms.
Vagina
The lamina propria of the mucosa is rich in elastic fibers and has numerous narrow papillae projecting into the epithelial layer.
The vaginal connective tissue normally contains lymphocytes and neutrophils in relatively large quantities.
The vaginal mucosa itself has few sensory nerve endings
Vagina
The muscular layer of the vagina is composed mainly of two indistinct layers of smooth muscle,
1.inner circular bundles next to the mucosa
2.outer thicker longitudinal bundles near the adventitial layer.
The dense connective tissue of the adventitia is rich in elastic fibers, making the vaginal wall strong and elastic while binding it the surrounding tissues.
This outer layer also contains an extensive venous plexus, lymphatics, and nerves
Vagina
Each mammary gland consists of 15–25 lobes of the compound tubuloalveolar type whose function is to secrete milk to nourish newborns.
Each lobe, separated from the others by dense connective tissue with much adipose tissue, is a separate gland with its own excretory lactiferous duct. These ducts emerge independently in the nipple, which has 15–25 openings.
Mammary Glands
The lactiferous sinuses are lined with stratified cuboidal epithelium
the lining of the lactiferous ducts and terminal ducts is simple cuboidal or columnar epithelium covered by closely packed myoepithelial cells. Sparse fibers of smooth muscle also encircle the larger ducts.The histologic structure of the mammary glands varies according to
sexage
and physiologic status (puberty, pregnancy, lactation, weaning and involution)
The mammary glands in both sexes are composed only of lactiferous sinuses with small, branching ducts emerging from these sinuses.
Mammary Glands before puberty
In girls undergoing puberty and having higher levels of circulating estrogens, the breasts increase in size as a result of adipocyte accumulation in the connective tissue and increased growth and branching of the duct system.
Mammary gland during Puberty
The mammary glands undergo growth during pregnancy as a result of the synergistic action of several hormones, mainly estrogen, progesterone, prolactin, and human placental lactogen. One result of these hormones is the proliferation of secretory alveoli at the ends of the intralobular ducts.
The spherical alveoli are composed of cuboidal epithelium, with stellate myoepithelial cells between the secretory cells and the basal lamina.
Mammary gland during pregnancy
Following parturition the glandular alveoli of the breasts increase greatly in size and become very active in milk production, primarily influenced by prolactin from the anterior pituitary.
Mammary gland during lactation
Epithelial cells of the alveoli enlarge and engage actively in synthesis of proteins and lipids for secretion
Proteins are made on rough ER, processed through the Golgi apparatus and packaged into secretory vesicles, which undergo exocytosis during merocrine secretion into the lumen.
Spherical lipid droplets form in the cytoplasm of the alveolar cells and pass out of the cells into the lumen by the process of apocrine secretion
When a woman is breast-feeding, the nursing action of the child stimulates tactile receptors in the nipple, resulting in liberation of the posterior pituitary hormone oxytocin . This hormone causes contraction of the smooth muscle of the lactiferous sinuses and ducts, as well as the myoepithelial cells of alveoli, resulting in the milk-ejection reflex. Negative emotional stimuli, such as frustration, anxiety, or anger, can inhibit the liberation of oxytocin and thus prevent the reflex.
MEDICAL APPLICATION
When breast-feeding is stopped (weaning), most alveoli that developed secretory properties during pregnancy degenerate.
The duct system of the gland returns to its general appearance in the inactive state before pregnancy.
After menopause, alveoli and ducts of the mammary glands are reduced further in size and there is some loss of fibro-blasts, collagen, and elastic fibers in the stroma
Postlactational Regression in the Mammary Glands
Most instances of breast cancer (mammary carcinomas) arise from epithelial cells of the lactiferous ducts.
Cell spreading (or metastasizing) from the carcinoma via the circulatory or lymphatic vessels to critical organs such as the lungs or brain are responsible for the mortality associated with breast cancer.
Axillary lymph nodes are removed surgically and examined histologically for the presence of metastatic mammary carcinoma cells.
MEDICAL APPLICATION
Early detection through
self-examinationMammography
ultrasound
and consequent early treatment have significantly reduced the mortality rate